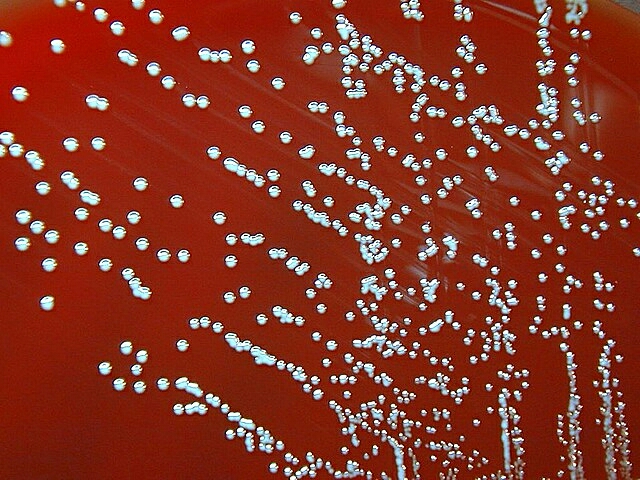

Saturday, September 30, 2023
Diabetes; The Urgent Need for Dietary Solutions
India is grappling with a diabetes epidemic, with over a million people affected by this metabolic condition. A recent Lancet study supported by the ICMR (Indian Council of Medical Research) highlights the alarming and continuously rising prevalence of metabolic health conditions, including diabetes.....https://indianf.com/diabetes-the-urgent-need-for-dietary-solutions/
ISRO’s Ambitious Venus Mission: ‘Shukrayaan-1’ on the Horizon
The Indian Space Research Organisation (ISRO), following the achievements of Chandrayaan-3 and the Aditya L-1 missions, is now poised to venture into the realm of Venus, often referred to as Earth’s twin through ‘Shukrayaan-1’ ......https://indianf.com/isros-ambitious-venus-mission-shukrayaan-1-on-the-horizon/
Wednesday, September 27, 2023
Generative AI: Opportunities and Challenges Revealed
Generative AI, the powerhouse of technological evolution, has surfaced as a potent double-edged sword, presenting both incredible opportunities and formidable challenges, as articulated by researchers from the esteemed Oxford Martin School....https://indianf.com/generative-ai-opportunities-and-challenges-revealed/
Exposure to toxic chemicals causing diverse health disorders
In the modern lifestyle, we are exposed to many toxic chemicals in our everyday life to meet our escalating material demands. As per an estimate, we come across about 500 chemical compounds daily, several being synthetic and toxic in nature. Many of these toxic chemicals have the potential to bring about severe health impacts not only in human beings but also in other living organisms existing in nature. Release of these chemicals into our environment also causes pollution of soil, water and air and these ultimately again reach the human body through the food chains....https://indianf.com/exposure-to-toxic-chemicals-causing-diverse-health-disorders/
Supercontinent Formation Could Render Earth ‘Uninhabitable to Mammalian Life
The eventual formation of the next supercontinent, often referred to as Pangea Ultima, could lead to conditions that are “uninhabitable to mammalian life”, according to a study led by researchers from the University of Bristol.....https://indianf.com/supercontinent-formation-could-render-earth-uninhabitable-to-mammalian-life/
Future Tourism through AI, Contactless Experiences, Sustainability
Travel has always been a blend of adventure and discovery, but as we step into the future, technology is poised to play an even more significant role in our journeys. From AI-powered travel planning to contactless experiences and sustainable transportation, the tourism industry is undergoing a profound transformation. In this article, we look into the exciting developments that are shaping the future of tourism....https://indianf.com/future-tourism-through-ai-contactless-experiences-sustainability/
Tuesday, September 26, 2023
African Rhino Numbers on the Rise despite Poaching Challenges
Despite the persistent threat of poaching, African rhino populations have shown a promising increase, with an estimated 23,290 rhinos on the continent by the end of 2022, marking a 5.2% growth from the previous year.....https://indianf.com/african-rhino-numbers-on-the-rise-despite-poaching-challenges/
Investing in infrastructure can stimulate economic growth
Majority of the people believe investing in infrastructure could stimulate economic growth and job creation but are cautious about delivery, increased taxation, and borrowing to fund such investments, according to a recent study.....https://indianf.com/investing-in-infrastructure-can-stimulate-economic-growth/
Science of Your Unique Scent: Unravelling the Secret
Your unique smell is a complex blend influenced by genetics and various factors......https://indianf.com/science-of-your-unique-scent-unravelling-the-secrets/
Monday, September 25, 2023
Human Activities Pushing Planetary Boundaries: Warning for Health of Planet
In a stark reminder of the consequences of human activities on our planet, a new study highlights the growing impact of these actions on Earth’s vital boundaries. These planetary boundaries represent the delicate balance that sustains the stability and liveability of the planet for all living beings.... https://indianf.com/human-activities-pushing-planetary-boundaries-warning-for-health-of-planet/
Thursday, September 21, 2023
DeepMind AlphaMissense: Accelerating Disease Gene Discovery
In a groundbreaking development, DeepMind, the AI firm under Google’s umbrella, has harnessed the power of artificial intelligence to pinpoint alterations in human DNA linked to various diseases....https://indianf.com/deepmind-alphamissense-accelerating-disease-gene-discovery/
Wednesday, September 20, 2023
Incurable Dog Disease Spreads to Humans in the UK –Know More
In a startling development, a dog disease previously believed to be confined to canines has infected three individuals in the United Kingdom... https://indianf.com/incurable-dog-disease-spreads-to-humans-in-the-uk-know-more/
Economic Outlook: Growth Slows, Inflation Persists, Risks Remain
The world economy is expected to see moderate growth in 2023, projected at 3.0%, but is anticipated to slow down slightly to 2.7% in 2024.....https://indianf.com/economic-outlook-growth-slows-inflation-persists-and-risks-remain/
Tuesday, September 19, 2023
250 Million Children Worldwide Deprived of Education
New figures released on Monday by the United Nations Educational, Scientific, and Cultural Organization (UNESCO) have revealed a troubling reality – the number of children worldwide who are deprived of any form of education has reached a staggering 250 million....https://indianf.com/250-million-children-worldwide-deprived-of-education/
Strawberry Girl Makeup Trend
The world of makeup is in a constant state of evolution, with emerging trends that capture the hearts of beauty enthusiasts worldwide.....https://indianf.com/strawberry-girl-makeup-trend-embracing-freshness-and-fruity-vibes/
Monday, September 18, 2023
Mixed Fortunes: First Year of African Cheetahs in India
One year ago, eight African cheetahs arrived in Kuno National Park, Madhya Pradesh, marking a significant step in India’s conservation efforts. The ambitious project aims to establish a viable cheetah metapopulation in India, allowing these magnificent creatures to play their role as top predators and expand within their historical range, contributing to global conservation. However, the journey has been marked by challenges and questions.....https://indianf.com/mixed-fortunes-first-year-of-african-cheetahs-in-india/
SpermSearch; AI in Male Infertility Treatment
Male infertility, a condition affecting more of the male population globally, has long presented challenges in diagnosis and treatment. In a remarkable breakthrough,
artificial intelligence (AI) is poised to revolutionize the field. SpermSearch, an AI-powered tool designed to address male infertility, boasts the ability to identify viable sperm in samples from extremely infertile men a stunning 1,000 times faster than human embryologists.....https://indianf.com/spermsearch-ai-in-male-infertility-treatment/
Unhealthy Snacking Habits Put Health at Risk
About 25 percent of people are negating the benefits of nutritious meals by indulging in detrimental snacks, significantly impacting their blood sugar and fat levels, according to a recent study.....https://indianf.com/unhealthy-snacking-habits-put-health-at-risk/
More Americans Believe Being a Man Helps than Hurts
More Americans say being a man helps than hurts a person’s ability to get ahead in the United States these days, according to a recent Pew Research Center survey. By contrast, more Americans say being a woman hurts rather than helps.....https://indianf.com/more-americans-believe-being-a-man-helps-than-hurts/
Kindergarten Conduct Problems Linked to Future Societal Costs
Sunday, September 17, 2023
Breathable Oxygen Extraction Feasibility on Mars
In a groundbreaking achievement, NASA’s Mars Oxygen In-Situ Resource Utilization (ISRU) Experiment (MOXIE) has demonstrated the feasibility of extracting breathable oxygen from the thin Martian atmosphere. After a series of successful experiments, MOXIE is now poised to conclude its mission, leaving behind valuable insights for future Mars exploration....https://indianf.com/breathable-oxygen-extraction-feasibility-on-mars/
Saturday, September 16, 2023
Warming and Oxygen Loss in Rivers Outpacing Oceans
Rivers are warming and losing oxygen faster than oceans, according to a Penn State-led study published today (Sept. 14) in the journal Nature Climate Change. The study shows that of nearly 800 rivers, warming occurred in 87% and oxygen loss occurred in 70%....https://indianf.com/warming-and-oxygen-loss-in-rivers-outpacing-oceans/
Friday, September 15, 2023
One in Six Children Lives in Extreme Poverty
About 333 million children, or 1 in 6, live in extreme poverty, enduring conditions of deprivation that encompass basic needs, dignity, opportunities, and hope, according to a report jointly released by the UN Children’s Fund (UNICEF) and the World Bank....https://indianf.com/one-in-six-children-lives-in-extreme-poverty/
Nearly One Child Born Every Second Faces Risk of Stunted Growth by 2030
About 194 million children born between now and 2030 are at risk of stunted growth if urgent action is not taken, warns Save the Children....https://indianf.com/nearly-one-child-born-every-second-faces-risk-of-stunted-growth-by-2030/
Extreme Weather Events Linked to Surge in Child Marriages
Among the negative impacts of extreme weather events around the world is one that most people may not think of: an increase in child marriages...,https://indianf.com/extreme-weather-events-linked-to-surge-in-child-marriages/
Wednesday, September 13, 2023
Climate Change Impacts Pathogen Prevalence in Birds and Bats
Many of the pathogens such as harmful protozoans, bacteria, and viruses among birds and bats exhibit a correlation with temperature and rainfall (climate change), according to a comprehensive Europe-wide study....https://indianf.com/climate-change-impacts-pathogen-prevalence-in-birds-and-bats/
Lions in Peril: Uncovering the Threats Facing African Lion Populations
While the estimated total population of wild lions in Africa ranges between 20,000 and 25,000 individuals, a concerning number of them reside in small, fragmented populations that are at risk of disappearing....https://indianf.com/lions-in-peril-uncovering-the-threats-facing-african-lion-populations/
Tuesday, September 12, 2023
Global Food Crisis Looms: UNWFP Warns of Catastrophic Impact
The United Nations World Food Programme (WFP) has issued a stark warning regarding global food security. Their estimation is chilling: even a mere one percent reduction in food assistance could push more than 400,000 individuals to the brink of starvation.....https://indianf.com/global-food-crisis-looms-unwfp-warns-of-catastrophic-impact/
Sands of Change: Global Marine Extraction Threatens Biodiversity
In a concerning revelation, the marine dredging industry is extracting a staggering six billion tons of sand annually, equivalent to over 1 million dump trucks’ worth per day. This massive extraction of sands and other sediments is exerting tremendous pressure on marine life and ecosystems, with far-reaching consequences for biodiversity and coastal communities.....https://indianf.com/sands-of-change-global-marine-extraction-threatens-biodiversity/
Widespread Species Shrinkage, with Fish among Most Affected
In a sweeping global analysis encompassing thousands of animal and plant species, a concerning trend has emerged: species across the board are shrinking in size. Researchers have pinpointed this phenomenon most prominently in fish, which are undergoing significant reductions in size.....https://indianf.com/widespread-species-shrinkage-with-fish-among-most-affected/
Subscribe to:
Posts (Atom)